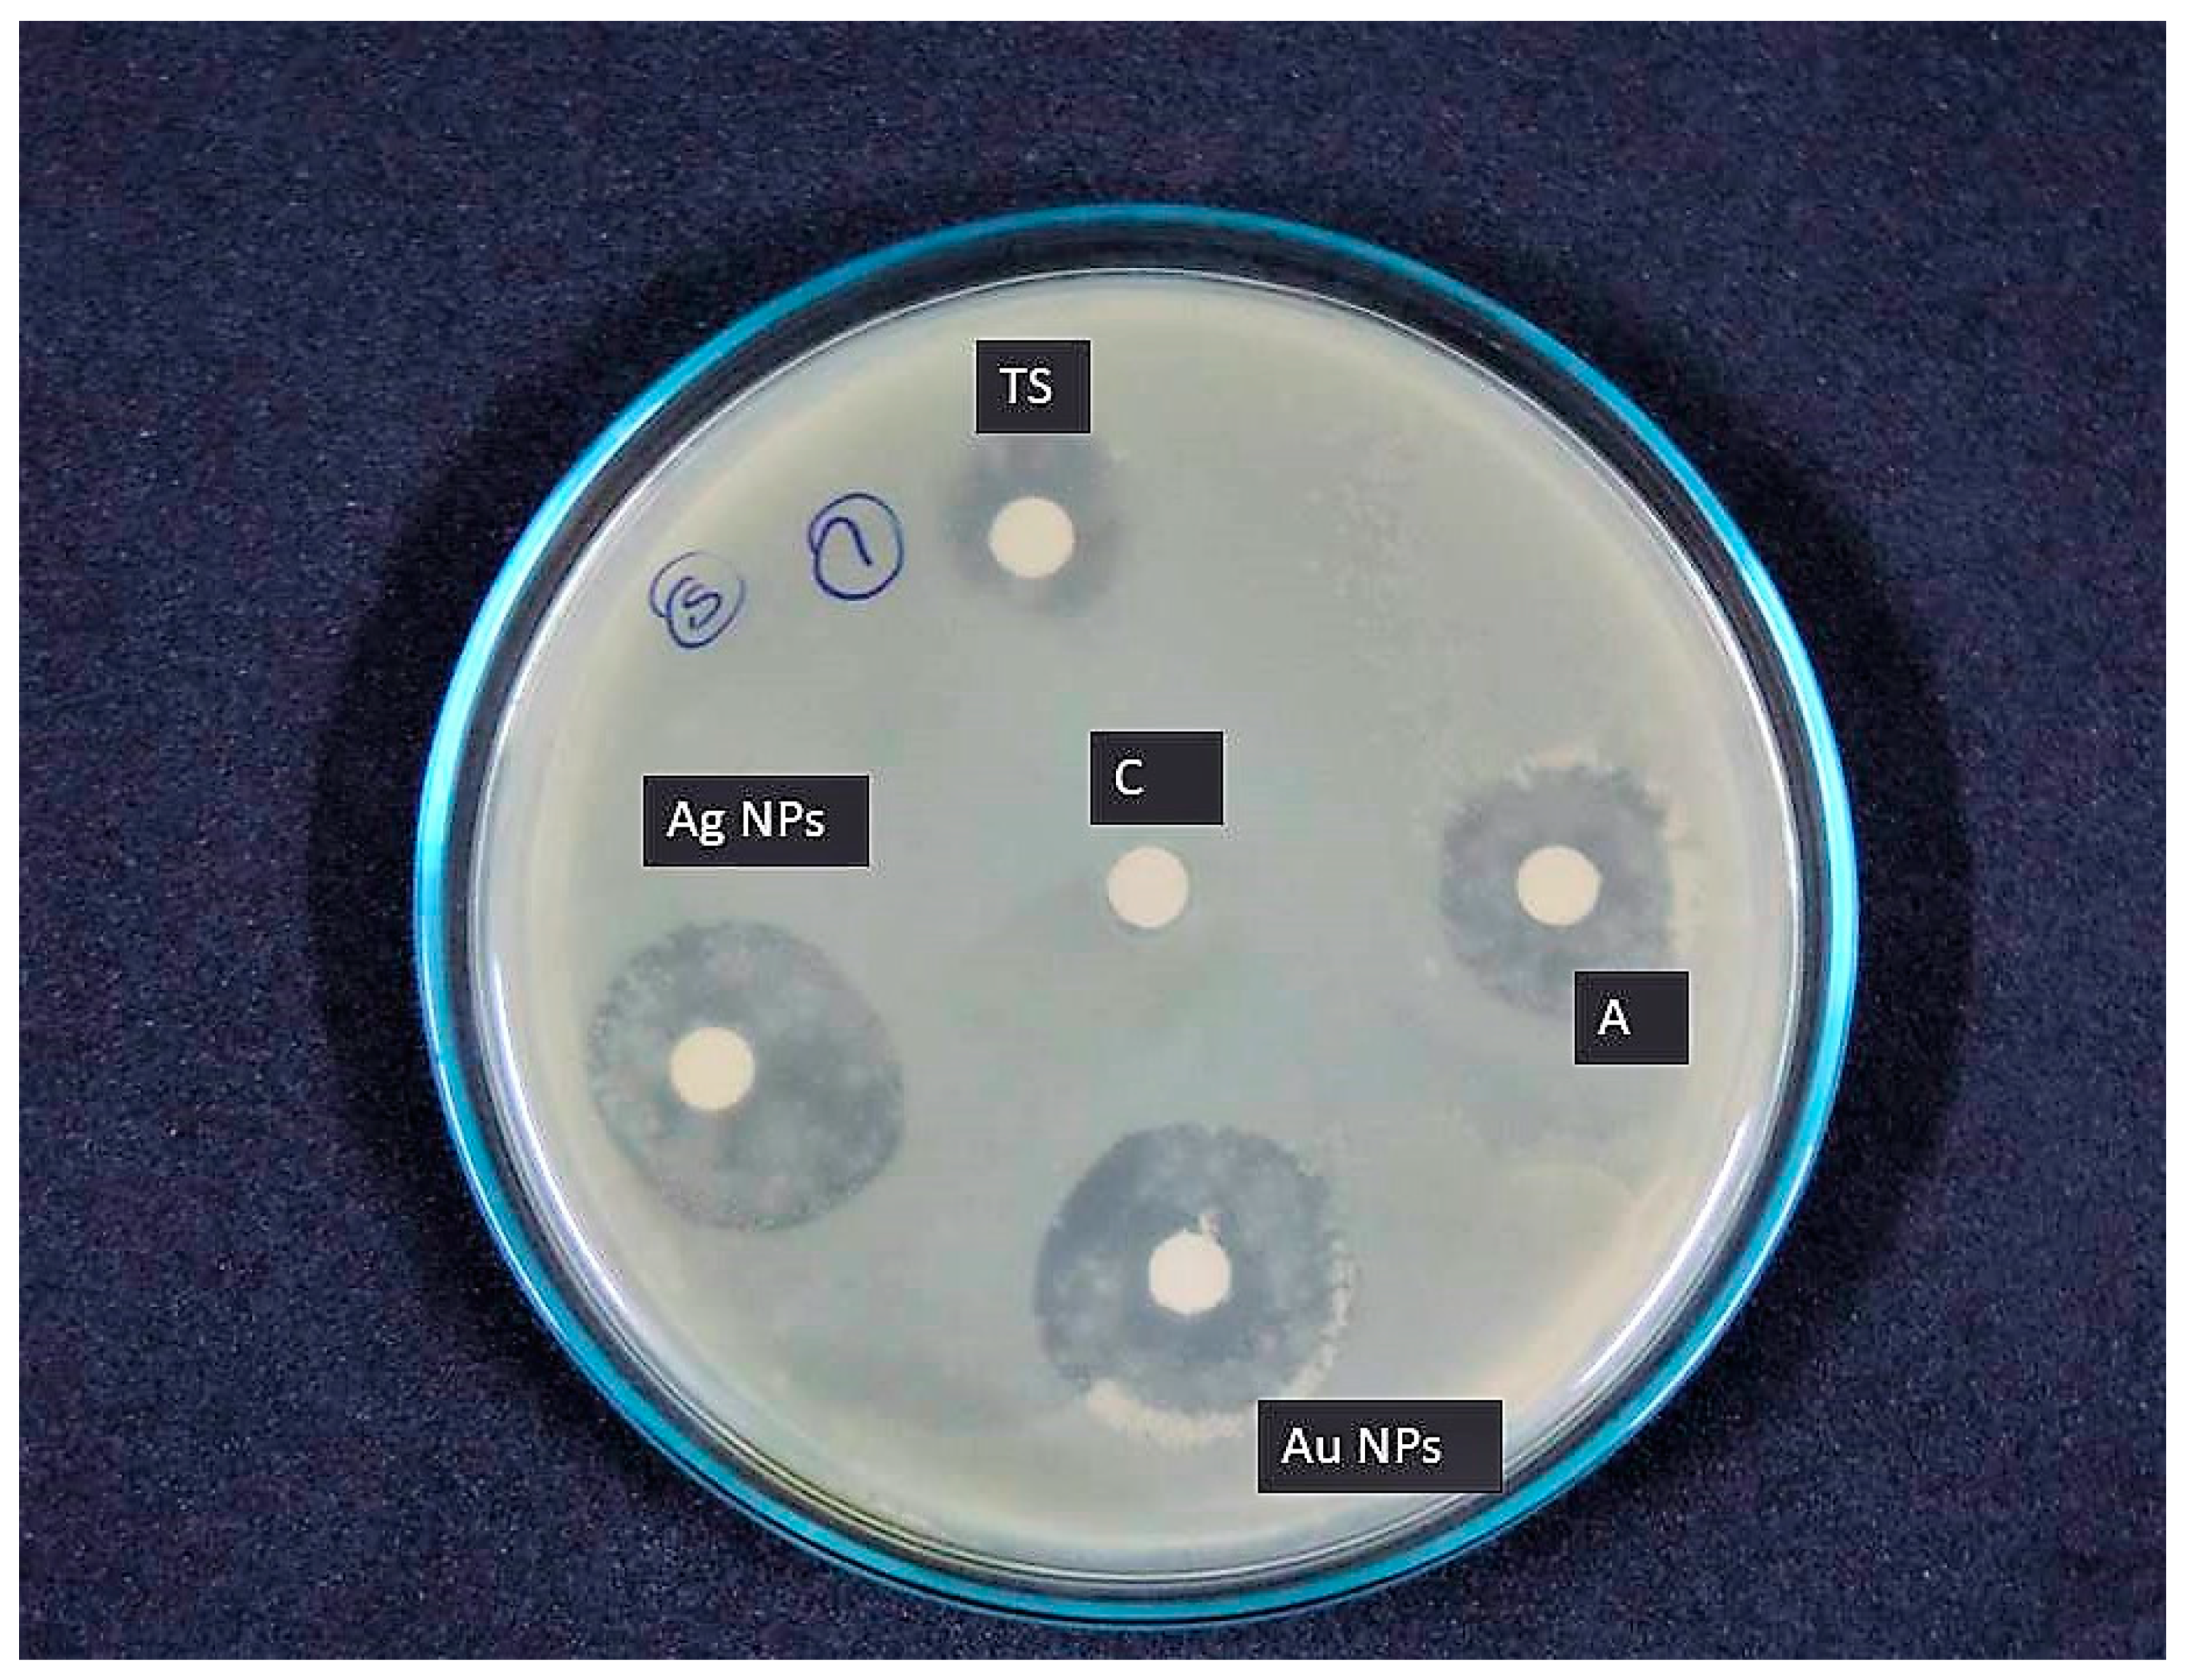
Jmse 09 00678 g010 Jmse 09 00678 g010

Isolation and Optimization of Culture Conditions of Thraustochytrium kinnei for Biomass Production, Nanoparticle Synthesis, Antioxidant and Antimicrobial Activities
Abstract
1. Introduction
2. Materials and Methods
2.1. Isolation and Maintenance of Thraustochytrids from Decomposing Mangrove Leaves
2.2. Morphological Identification of Thraustochytrids Species
2.3. Genomic DNA Extraction and PCR Amplification of Thraustochytrids
2.4. Sequencing and Phylogenetic Analyses of 18S rRNA Gene
2.5. Mass Production of Thraustochytrid
2.6. Prediction of Important Factors for Biomass Production Using Plackett-Burman Design
2.7. Optimization of Media Components for Maximm Biomass Production by Using Central Composite Design (CCD)
X1X2 + β13 X1X3 + β14 X1X4 + β23 X2X3 + β24 X2X4 + β34 X3X4
2.8. Lipid and Fatty Acid Methyl Ester (FAME) Extraction and Analysis
2.9. Biosynthesis of Silver Nanoparticles
2.10. Biosynthesis of Gold Nanoparticles
2.11. Characterization of Nanoparticles: SEM and Dynamic Light Scattering (DLS) Analysis
2.12. In Vitro Antioxidant Assays of Nanoparticles
2.12.1. Total Antioxidant Capacity (TAC)
2.12.2. DPPH Radical Scavenging Activity
2.13. In Vitro Antibacterial Activity of Nanoparticles
3. Results
3.1. Morphological and Molecular Identification
3.2. Selection of the Important Factors and Their Optimization for Biomass Production
− 0.208C + 0.485D − 0.381AB − 0.086AC + 0.058AD + 0.173BC − 0.041BD −
0.088CD − 3.113A2 − 2.566B2 − 1.868C2 − 1.965D2
3.3. Lipid and Fatty Acid Profiles of Thraustochytrid
3.4. Synthesis and Characterization of Silver and Gold Nanoparticles
3.5. Antioxidant Activity
3.6. Antibacterial Activity
4. Discussion
5. Conclusions
Author Contributions
Funding
Institutional Review Board Statement
Informed Consent Statement
Data Availability Statement
Acknowledgments
Conflicts of Interest
References
- Caamano, E.; Loperena, L.; Hinzpeter, I.; Pradel, P.; Gordillo, F.; Corsini, G.; Tello, M.; Lavini, P.; Gonzaleza, A.R. Isolation and molecular characterization of Thraustochytrium strain isolated from Antarctic Peninsula and its biotechnological potential in the production of fatty acids. Brazil. J. Microbiol. 2017, 48, 671–679. [Google Scholar] [CrossRef]
- Kalidasan, K.; Sunil, K.S.; Kayalvizhi, K.; Kathiresan, K. Polyunsaturated fatty acid-producing marine thraustochytrids: A potential source for antimicrobials. J. Coast. Life Med. 2015, 3, 848–851. [Google Scholar] [CrossRef]
- Kalidasan, K.; Sunil, K.S.; Narendran, R.; Kathiresan, K. Antioxidant activity of mangrove-derived marine thraustochytrids. Mycosphere 2015, 6, 602–611. [Google Scholar] [CrossRef]
- Marchan, F.L.; Chang, K.J.L.; Nichols, P.D.; Mitchell, W.J.; Polglase, J.L.; Gutierrez, T. Taxonomy, ecology and biotechnolog -ical applications of thraustochytrids: A Review. Biotechnol. Adv. 2017, 36, 26–46. [Google Scholar] [CrossRef] [PubMed]
- Singh, A.; Ward, O.P. Omega-3/6 fatty acids: Alternative sources of production. Process. Biochem. 2005, 40, 3627–3652. [Google Scholar]
- Colomer, R.; Moreno-Nogueira, J.M.; Garcia-Luna, P.P.; Garcia-Peris, P.; Garcia-de-Lorenzo, A.; Zarazaga, A.; Quecedo, L.; del Llano, J.; Usan, L.; Casimiro, C. N-3 fatty acids, cancer and cachexia: A systematic review of the literature. Br. J. Nutr. 2007, 97, 823–831. [Google Scholar] [CrossRef]
- Swanson, D.; Block, R.; Mousa, S. Omega-3 fatty acids EPA and DHA: Health benefits throughout life. Adv. Nutr. An Int. Rev. J. 2012, 3, 1–7. [Google Scholar] [CrossRef]
- Takahata, K.; Monobe, K.; Tada, M.; Weber, P.C. The benefits and risks of n-3 polyunsaturated fatty acids. Biosci. Biotechnol. Biochem. 1998, 62, 2079–2085. [Google Scholar] [CrossRef]
- Horrocks, L.; Farooqui, A. Docosahexaenoic acid in the diet: Its importance in maintenance and restoration of neural membrane function. Prostaglandins Leukot. Essent. Fat. Acids 2004, 70, 361–372. [Google Scholar] [CrossRef]
- Nakahara, T.; Yakochi, T.; Higashihara, S.; Tanaki, T.; Yaguchi, T.; Honda, D. Production of docosahexaenoic and docosapentaenoic acids by Schizochytrium sp. isolated from Yap Island. J. Am. Oil Chem. Soc. 1996, 73, 1421–1426. [Google Scholar] [CrossRef]
- Manikan, K.V.; Hamid, M.S.; Abdul, A. Response surface optimization of culture medium for enhanced docosahexaenoic acid production by a Malaysian thraustochytrid. Sci. Rep. 2015, 5, 8611. [Google Scholar] [CrossRef]
- Sahin, D.; Tas, E.; Altindag, U.H. Enhancement of docosahexaenoic acid (DHA) production from Schizochytrium sp. S31 using different growth medium conditions. AMB Exp. 2018, 8, 7. [Google Scholar] [CrossRef]
- Nazir, Y.; Shuib, S.; Kalil, M.S.; Song, Y.; Hamid, A.A. Optimization of Culture Conditions for Enhanced Growth, Lipid and Docosahexaenoic Acid (DHA) Production of Aurantiochytrium SW1 by Response Surface Methodology. Sci. Rep. 2018, 8, 8909. [Google Scholar] [CrossRef] [PubMed]
- Murali, S.; Ahmad, A.; Khan, M.I.; Rajiv, K. Biosynthesis of metal nanoparticles using fungi and actinomycete. Curr. Sci. 2003, 85, 162–170. [Google Scholar]
- Rai, M.; Ingle, A.P.; Gaikwad, S.; Gupta, I.; Gade, A.; Silvério da Silva, S. Nanotechnology based anti-infective to fight microbial intrusions. J. Appl. Microbiol. 2016, 120, 527–542. [Google Scholar] [CrossRef]
- Saratale, R.G.; Saratale, G.D.; Shin, H.S.; Jacob, J.M.; Pugazhendhi, A.; Bhaisare, M.; Kumar, G. New insights on the green synthesis of metallic nanoparticles using plant and waste biomaterials: Current knowledge, their agricultural and environmental applications. Environ. Sci. Pollut. Res. 2017, 11, 10164–10183. [Google Scholar] [CrossRef] [PubMed]
- Mohanpuria, P.; Rana, N.K.; Yadav, S.K. Biosynthesis of nanoparticles: Technological concepts and future applications. J. Nanopart. Res. 2008, 10, 507–517. [Google Scholar] [CrossRef]
- Wypij, M.; Czarnecka, J.; Świecimska, M.; Dahm, H.; Rai, M.; Golinska, P. Synthesis, characterization and evaluation of antimicrobial and cytotoxic activities of biogenic silver nanoparticles synthesized from Streptomyces xinghaiensis OF1 strain. World J. Microbiol. Biotechnol. 2018, 34, 23. [Google Scholar] [CrossRef] [PubMed]
- Shankar, P.D.; Shobana, S.; Karuppusamy, I.; Pugazhendhi, A.; Ramkumar, V.S.; Arvindnarayan, S.; Kumar, G. A review on the biosynthesis of metallic nanoparticles (gold and silver) using bio-components of microalgae: Formation mechanism and applications. Enzym. Microb. Technol. 2016, 95, 28–44. [Google Scholar] [CrossRef]
- Ramkumar, V.S.; Pugazhendhi, A.; Gopalakrishnan, K.; Sivagurunathan, P.; Saratale, G.D.; Dung, T.N.B.; Kannapiran, E. Bio fabrication and characterization of silver nanoparticles using aqueous extract of seaweed Enteromorpha compressa and its biomedical properties. Biotechnol. Rep. 2017, 14, 1–7. [Google Scholar] [CrossRef]
- Visudtiphole, V.; Phromson, M.; Tala, S.; Bunphimpapha, P.; Raweeratanapong, T.; Sittikankaew, K.; Arayamethakorn, S.; Preedanon, S.; Jangsutthivorawat, W.; Chaiyapechara, S.; et al. Aurantiochytrium limacinum BCC52274 improves growth, hypo-salinity tolerance and swimming strength of Penaeus vannamei post larvae. Aquaculture 2018, 495, 849–857. [Google Scholar] [CrossRef]
- Chen, C.Y.; Lee, M.H.; Leong, Y.K.; Chang, J.S.; Lee, D.J. Biodiesel production from heterotrophic oleaginous microalga Thraustochytrium sp. BM2 with enhanced lipid accumulation using crude glycerol as alternative carbon source. Bioresour. Technol. 2020, 306, 123113. [Google Scholar] [CrossRef] [PubMed]
- Bongiorni, L.; Pusceddu, A.; Danovaro, R. Enzymatic activities of epiphytic and benthic thraustochytrids involved inorganic matter degradation. Aquat. Microb. Ecol. 2005, 41, 299–305. [Google Scholar] [CrossRef]
- Park, H.; Kwak, M.; Seo, J.; Ju, J.; Heo, S.; Park, S.; Hong, W. Enhanced production of carotenoids using a Thraustochytrid microalgal strain containing high levels of docosahexaenoic acid-rich oil. Bioprocess Biosyst. Eng. 2018, 41, 1355–1370. [Google Scholar] [CrossRef]
- Patel, A.; Liefeldt, S.; Rova, U.; Christakopoulos, P.; Matsakas, L. Co-production of DHA and squalene by thraustochytrid from forest biomass. Sci. Rep. 2020, 10, 1992. [Google Scholar] [CrossRef]
- Xiao, R.; Xi, Y.; Mi, L.; Xiang, L.; Yanzhang, W.; Min, C.; Arthur, R.; Mark, T.; Junhuan, D.; Yi, Z. Investigation of Composition, Structure and Bioactivity of Extracellular Polymeric Substances from Original and Stress-induced Strains of Thraustochytrium striatum. Carbohyd. Polymer 2018, 195, 515–524. [Google Scholar] [CrossRef]
- Ramos-Vega, A.; Rosales-Mendoza, S.; Bañuelos-Hernández, B.; Angulo, C. Prospects on the Use of Schizochytrium sp. to Develop Oral Vaccines. Front. Microbiol. 2018, 9, 2506. [Google Scholar] [CrossRef]
- Shakeri, S.; Amoozyan, N.; Fekrat, F.; Maleki, M. Antigastric cancer bioactive Aurantiochytrium oil rich in Docosahexaenoic acid: From media optimization to cancer cells cytotoxicity assessment. J. Food. Sci. 2017, 82, 2706–2718. [Google Scholar] [CrossRef]
- Schmitt, D.; Tran, N.; Peach, J.; Edwards, T.; Greeley, M. Toxicologic evaluations of DHA-rich algal oil in rats: Developmental toxicity study and 3-month dietary toxicity study with an in utero exposure phase. Food Chem. Toxicol. 2012, 50, 4149–4157. [Google Scholar] [CrossRef]
- Asmathunisha, N.; Kathiresan, K. A review on biosynthesis of nanoparticles by marine organisms. Colloids. Surf. B Biointerfaces 2013, 103, 283–287. [Google Scholar] [CrossRef]
- Ravinder Singh, C.; Kathiresan, K.; Anandhan, S. A review on marine based nanoparticles and their potential applications. Afr. J. Biotechnol. 2015, 14, 1525–1532. [Google Scholar] [CrossRef]
- Raghukumar, S. Ecology of the marine protists, the labyrinthulomycetes (thraustochytrids and labyrinthulids). Eur. J. Protistol. 2002, 38, 127–145. [Google Scholar] [CrossRef]
- Mo, J.C.; Rinkevich, D.B. Development of a PCR strategy for thraustochytrid identification based on 18S rDNA sequence. Mar. Biol. 2002, 140, 883–889. [Google Scholar] [CrossRef]
- Honda, D.; Yokochi, T.; Nakahara, T.; Raghukumar, S.; Nakagiri, A.; Schaumann, K.; Higashihara, T. Molecular phylogeny of labyrinthulids and thraustochytrids based on the sequencing of 18S ribosomal RNA gene. J. Eukaryot. Microbiol. 1999, 46, 637–647. [Google Scholar] [CrossRef] [PubMed]
- Tamura, K.; Stecher, G.; Peterson, D.; Filipski, A.; Kumar, S. MEGA6: Molecular Evolutionary Genetics Analysis version 6.0. Mol. Biol. Evol. 2013, 30, 2725–2729. [Google Scholar] [CrossRef]
- Folch, J.; Lees, M.; Sloane Stanley, G.H. A simple method for the isolation and purification of the total lipids from animal tissues. J. Biol. Chem. 1957, 226, 497–509. [Google Scholar] [CrossRef]
- Sasser, M. Identification of Bacteria by Gas Chromatography of Cellular Fatty Acids; MIDI Technical Note #101: Newark, DE, USA, 1990. [Google Scholar]
- Yu, J.H.; Wang, Y.; Sun, J.; Bian, F.; Chen, G.; Zhang, Y.; Bi, Y.P.; Wu, Y.J. Antioxidant activity of alcohol aqueous extracts of Crypthecodinium cohnii and Schizochytrium sp. J. Zhejiang Univ. Sci. B 2017, 18, 797–806. [Google Scholar] [CrossRef]
- Booth, T.; Miller, C.E. Comparative morphologic and taxonomic studies in the genus Thraustochytrium. Mycologia 1968, 60, 480–495. [Google Scholar] [CrossRef]
- Wethered, J.M.; Jennings, D.H. Major solutes contributing to solute potential of Thraustochytrium aureum and T. roseum after growth in media of different salinities. Trans. Br. Mycol. Soc. 1985, 85, 439–446. [Google Scholar] [CrossRef]
- Yaguchi, T.; Tanaka, S.; Yokochi, T.; Nakahara, T.; Higashihara, T. Production of high yields of docosahexaenoic acid by Schizochytrium sp. strain SR21. J. Am. Oil Chem. Soc. 1997, 74, 143–1434. [Google Scholar] [CrossRef]
- Iida, I.; Nakahara, T.; Yokochi, T.; Kamisaka, Y.; Yagi, H.; Yamaoka, M.; Suzuki, O. Improvement of docosahexaenoic acid production in a culture of Thraustochytrium aureum by medium optimization. J. Ferment. Bioeng. 1996, 81, 76–78. [Google Scholar] [CrossRef]
- Weete, J.D.; Kim, H.; Gandhi, S.R.; Wang, Y.; Dute, R. Lipids and ultrastructure of Thraustochytrium sp. Lipids 1997, 32, 839–845. [Google Scholar] [CrossRef]
- Kabilan, C.; Roy, R.K.; Chadha, A. Docosahexaenoic acid production by a novel high yielding strain of Thraustochytrium sp. of Indian origin: Isolation and bioprocess optimization studies. Algal Res. 2018, 32, 93–100. [Google Scholar] [CrossRef]
- Mandal, D.; Bolander, M.E.; Mukhopadhyay, D.; Sarkar, G.; Mukherjee, P. The use of microorganisms for the formation of metal nanoparticles and their application. Appl. Microbiol. Biotechnol. 2006, 69, 485–492. [Google Scholar] [CrossRef] [PubMed]
- Gomathi, V. Studies on Thraustochytrids of Mangrove Sediments for Poly Unsaturated Fatty Acids and Nanoparticles Synthesis. Master’s Thesis, Annamai University, Tamil Nadu, India, 2009; pp. 63–65. [Google Scholar]
- Vahabi, K.; Ali Mansoori, G.; Karimi, S. Biosynthesis of silver nanoparticles by fungus Trichoderma Reesei. Insci. J. 2011, 1, 65–79. [Google Scholar] [CrossRef]
- Plaza, M.; Herrero, M.; Cifuentes, A.; Ibanez, E. Innovative natural functional ingredients from microalgae. J. Agric. Food Chem. 2009, 57, 7159–7170. [Google Scholar] [CrossRef] [PubMed]
- Phanjom, P.; Ahmed, G. Effect of different physicochemical conditions on the synthesis of silver nanoparticles using fungal cell filtrate of Aspergillus oryzae (MTCC No. 1846) and their antibacterial effects. Adv. Nat. Sci. Nanosci. Nanotechnol. 2017, 8. [Google Scholar] [CrossRef]
- Taoka, Y.; Nagano, N.; Kai, H.; Hayashi, M. Degradation of distillery lees (shochukasu) by cellulose-producing thraustochytrids. J. Oleo Sci. 2017, 66, 31–40. [Google Scholar] [CrossRef][Green Version]
- Zhang, H.; Zhang, L.; Peng, L.; Dong, X.; Wu, D.; Wu, V.C.; Feng, F. Quantitative structure activity relationships of antimicrobial fatty acids and derivatives against Staphylococcus aureus. J. Zhejiang Univ. Sci. B 2012, 13, 83–93. [Google Scholar] [CrossRef]
- Manjunath, H.M.; Joshi, C.G. Characterization, antioxidant and antimicrobial activity of silver nanoparticles synthesized using marine endophytic fungus Cladosporium cladosporioides. Process. Biochem. 2019, 82, 199–204. [Google Scholar] [CrossRef]

| Factor | Range and Coded Value | ||||
|---|---|---|---|---|---|
| −2 | −1 | 0 | 1 | 2 | |
| Temperature (°C) | 25 | 27.5 | 30 | 32.5 | 35 |
| pH | 5 | 6 | 7 | 8 | 9 |
| Salinity (ppt) | 20 | 25 | 30 | 35 | 40 |
| Days of incubation | 2 | 4 | 6 | 8 | 10 |
| Glucose | 10 | 15 | 20 | 25 | 30 |
| Sugarcane molasses | 10 | 15 | 20 | 25 | 30 |
| Bread crumbs | 10 | 15 | 20 | 25 | 30 |
| Yeast extracts (g·L−1) | 5 | 7.5 | 10 | 12.5 | 15 |
| Peptone (g·L−1) | 5 | 7.5 | 10 | 12.5 | 15 |
| Monosodium glutamate (g·L−1) | 5 | 7.5 | 10 | 12.5 | 15 |
| Factors | Biomass Production by Thraustochytrid Strain TSKK1 (g·dry wt·L−1) | ||
|---|---|---|---|
| Coefficient | Actual | Probability | |
| Intercept | 3.66 | 3.05 | 0.1150 |
| Temperature (°C) | −0.090 | 0.37 | 0.5676 |
| pH | 0.14 | 0.87 | 0.3926 |
| Salinity (ppt) | −0.43 | 8.79 | 0.0314 |
| Days of incubation | 0.25 | 2.85 | 0.1519 |
| Glucose | −0.046 | 0.097 | 0.7684 |
| Sugarcane molasses | −0.062 | 0.18 | 0.6915 |
| Bread crumbs | 0.50 | 11.52 | 0.0194 |
| Yeast extracts (g·L−1) | −0.29 | 3.90 | 0.1054 |
| Peptone (g·L−1) | 0.12 | 0.72 | 0.4342 |
| Monosodium glutamate (g·L−1) | −0.16 | 1.22 | 0.3201 |
| Run Order | (A) pH | (B) Days of Incubation | (C) Bread Crumbs (g·L−1) | (D) Peptone (g·L−1) | Biomass of Thraustochytrid Strain TSKK1 (g·dry wt·L−1) | |
|---|---|---|---|---|---|---|
| Experimental | Predicted | |||||
| 1 | 7 | 6 | 40 | 10 | 3.25 | 3.393 |
| 2 | 9 | 2 | 30 | 15 | 3.43 | 3.587 |
| 3 | 9 | 2 | 10 | 15 | 4.79 | 4.844 |
| 4 | 5 | 2 | 10 | 5 | 3.59 | 3.513 |
| 5 | 5 | 2 | 30 | 15 | 2.77 | 2.624 |
| 6 | 7 | 6 | 20 | 10 | 2.49 | 2.473 |
| 7 | 7 | 6 | 20 | 20 | 4.83 | 4.769 |
| 8 | 5 | 2 | 10 | 15 | 2.78 | 3.094 |
| 9 | 5 | 10 | 10 | 15 | 4.34 | 4.152 |
| 10 | 5 | 10 | 30 | 15 | 4.43 | 4.581 |
| 11 | 9 | 2 | 0 | 5 | 5.33 | 5.438 |
| 12 | 5 | 2 | 30 | 5 | 4.07 | 4.342 |
| 13 | 9 | 10 | 10 | 15 | 3.57 | 3.738 |
| 14 | 7 | −2 | 20 | 10 | 3.75 | 3.822 |
| 15 | 9 | 10 | 30 | 5 | 5.75 | 5.719 |
| 16 | 9 | 2 | 30 | 5 | 4.33 | 4.278 |
| 17 | 9 | 10 | 10 | 5 | 1.62 | 1.705 |
| 18 | 9 | 10 | 30 | 15 | 0.76 | 0.458 |
| 19 | 7 | 6 | 20 | 10 | 2.38 | 2.318 |
| 20 | 11 | 6 | 20 | 10 | 4.38 | 4.225 |
| 21 | 3 | 6 | 20 | 10 | 6.68 | 6.478 |
| 22 | 7 | 6 | 20 | 10 | 5.66 | 5.645 |
| 23 | 7 | 6 | 20 | 10 | 4.78 | 4.705 |
| 24 | 5 | 10 | 10 | 5 | 6.79 | 6.648 |
| 25 | 7 | 6 | 20 | 10 | 13.68 | 13.537 |
| 26 | 5 | 10 | 30 | 5 | 13.59 | 13.537 |
| 27 | 7 | 6 | 20 | 0 | 13.59 | 13.537 |
| 28 | 7 | 6 | 20 | 10 | 13.51 | 13.537 |
| 29 | 7 | 6 | 0 | 10 | 13.49 | 13.537 |
| 30 | 7 | 14 | 20 | 10 | 13.36 | 13.537 |
| Source | Sum of Squares | Df | Mean Square | F Value | p-Value Prob > F |
|---|---|---|---|---|---|
| Model | 484.295 | 14 | 34.592 | 848.3758 | 0.0001 *** |
| A—pH | 2.331 | 1 | 2.331 | 57.17392 | 0.0001 *** |
| B—Days of incubation | 5.453 | 1 | 5.453 | 133.735 | 0.0001 *** |
| C—Bread crumbs | 1.041 | 1 | 1.042 | 25.546 | 0.0001 *** |
| D—Peptone | 5.664 | 1 | 5.664 | 138.928 | 0.0001 *** |
| AB | 2.325 | 1 | 2.325 | 57.035 | 0.0001 *** |
| AC | 0.119 | 1 | 0.119 | 2.919 | 0.1081 NS |
| AD | 0.055 | 1 | 0.055 | 1.354 | 0.2627 NS |
| BC | 0.483 | 1 | 0.483 | 11.846 | 0.0036 ** |
| BD | 0.027 | 1 | 0.027 | 0.667 | 0.4266 NS |
| CD | 0.126 | 1 | 0.126 | 3.090 | 0.0991 NS |
| A2 | 265.932 | 1 | 265.932 | 6521.939 | 0.0001 *** |
| B2 | 180.634 | 1 | 180.634 | 4430.035 | 0.0001 *** |
| C2 | 95.786 | 1 | 95.786 | 2349.155 | 0.0001 *** |
| D2 | 105.907 | 1 | 105.907 | 2597.373 | 0.0001 *** |
| Residual | 0.611 | 15 | 0.040 | ||
| Lack of Fit | 0.551 | 10 | 0.055 | 4.568 | 0.0537 |
| Pure Error | 0.0603 | 5 | 0.012 | ||
| Cor Total | 484.906 | 29 |
| Carbon Atom of Fatty Acid | Name of the Fatty Acid | Content (%) |
|---|---|---|
| C11:0 | cis-10-undecanoic acid, methyl ester | 0.08 |
| C12:0 | cis-10-dodecanoic acid, methyl ester | 0.02 |
| C13: | cis-12-tridecanoic acid, methyl ester | 0.11 |
| C14: | Tetradecanoic acid, methyl ester | 5.31 |
| C14:1 | cis-13-Tetradecanoic acid, methyl ester | 0.48 |
| C15: | Pentadecanoic acid, methyl ester | 1.15 |
| C16: | Hexadecanoic acid, methyl ester | 31.81 |
| C16:1 | 9-Hexadecenoic acid, methyl ester | 0.79 |
| C16:3 | cis-7,10,13-Hexadecatrienoic acid, methyl ester | 0.06 |
| C17:1 | cis-16-heptadecanoic acid, methyl ester | 0.67 |
| C18: | Octadecanoic acid, methy ester | 4.82 |
| C18:1 | cis-13-octadecenoic acid, methy ester | 2.96 |
| C18:3 | cis-9,12,15-Octadecatrienoic acid, methyl ester | 0.33 |
| C20: | Eicosanoic acid, methyl ester | 0.38 |
| C20:3 | Methyl 7,11,14-eicosatrienoic acid, methyl ester | 0.33 |
| C20:4 | cis-8,11,14,17-eicosatetraenoic acid, methyl ester | 1.67 |
| C20:5 | cis-5,8,11,14,17-eicosapentaenoic acid, methyl ester | 7.76 |
| C21:5 | cis-20-heneicosanoic acid, methyl ester | 0.02 |
| C22:5 | cis-7,10,13,16,19-docosapentaenoic acid, methyl ester | 2.09 |
| C22:6 | cis-4,7,10,13,16,19-Docosahexaenoic acid, methyl ester | 39.16 |
| Clinical Pathogen | TS | AgNPs | AuNPs | Ampicillin + ve (C) |
|---|---|---|---|---|
| Proteus mirabilis | 10.33 ± 1.52 | 14.05 ± 1.00 | 11.23 ± 1.15 | 19 ± 0.57 |
| Staphylococcus aureus | 13.10 ± 1.00 | 16.07 ± 2.00 | 19.78 ± 2.08 | 17 ± 1.15 |
| Streptococcus pyogens | 7.62 ± 1.52 | 10.41 ± 1.15 | 9.31 ± 0.57 | 14 ± 1.52 |
| Escherichia coli | 6.69 ± 0.57 | 9.28 ± 1.36 | 8.06 ± 1.00 | 20 ± 2.08 |
| Vibrio parahaemolyticus | 8.32 ± 1.15 | 12.65 ± 1.43 | 12.11 ± 1.15 | 17 ± 1.15 |
| Vibrio cholera | 7.00 ± 2.30 | 9.60 ± 2.08 | 9.87 ± 1.52 | 16 ± 1.00 |
| Klebsiella pneumonia | 12.87 ± 1.13 | 22.16 ± 1.52 | 21.84 ± 2.00 | 19 ± 2.00 |
| Klebsiella oxytoca | 7.66 ± 0.57 | 12.10 ± 2.00 | 13.73 ± 2.08 | 16 ± 1.00 |
| Salmonella typhi | 8.61 ± 1.73 | 9.69 ± 2.36 | 12.66 ± 1.52 | 21 ± 1.52 |
| Salmonella paratyphi | 11.22 ± 2.00 | 17.33 ± 0.57 | 14.17 ± 2.81 | 20 ± 1.73 |
Publisher’s Note: MDPI stays neutral with regard to jurisdictional claims in published maps and institutional affiliations. |
© 2021 by the authors. Licensee MDPI, Basel, Switzerland. This article is an open access article distributed under the terms and conditions of the Creative Commons Attribution (CC BY) license (https://creativecommons.org/licenses/by/4.0/).
Share and Cite
Kalidasan, K.; Asmathunisha, N.; Gomathi, V.; Dufossé, L.; Kathiresan, K. Isolation and Optimization of Culture Conditions of Thraustochytrium kinnei for Biomass Production, Nanoparticle Synthesis, Antioxidant and Antimicrobial Activities. J. Mar. Sci. Eng. 2021, 9, 678. https://doi.org/10.3390/jmse9060678
Kalidasan K, Asmathunisha N, Gomathi V, Dufossé L, Kathiresan K. Isolation and Optimization of Culture Conditions of Thraustochytrium kinnei for Biomass Production, Nanoparticle Synthesis, Antioxidant and Antimicrobial Activities. Journal of Marine Science and Engineering. 2021; 9(6):678. https://doi.org/10.3390/jmse9060678
Chicago/Turabian StyleKalidasan, Kaliyamoorthy, Nabikhan Asmathunisha, Venugopal Gomathi, Laurent Dufossé, and Kandasamy Kathiresan. 2021. "Isolation and Optimization of Culture Conditions of Thraustochytrium kinnei for Biomass Production, Nanoparticle Synthesis, Antioxidant and Antimicrobial Activities" Journal of Marine Science and Engineering 9, no. 6: 678. https://doi.org/10.3390/jmse9060678
APA StyleKalidasan, K., Asmathunisha, N., Gomathi, V., Dufossé, L., & Kathiresan, K. (2021). Isolation and Optimization of Culture Conditions of Thraustochytrium kinnei for Biomass Production, Nanoparticle Synthesis, Antioxidant and Antimicrobial Activities. Journal of Marine Science and Engineering, 9(6), 678. https://doi.org/10.3390/jmse9060678

